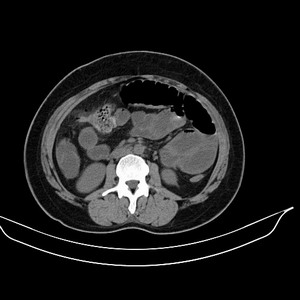

女 42岁 子宫肌瘤于外院术后两天,感腹胀。x线提示肠梗阻。 乡医发言:   zrs发言: 难倒是手术时留下了什么东西? 扬仪发言: 楼主的片子很有意思!好大个烟雾弹…… 子宫肌瘤于外院术后两天,出现肠扭转梗阻,很明显。但右下腹部出现的线状高密度,是什么呢?有什么手术会有这样的物品呢?不会把电刀的导线遗留在腹腔吧!? 有可能是患者发现子宫肌瘤前就确诊了,右下腹线状高密度,不存在手术的意义(子宫肌瘤术中没有取出)。 意见如下图:考虑为寄生虫钙化  结果: 结果:术后纱布遗留,术后麻痹性肠梗阻肠梗阻  上面的图像是我们从手术室拿来的纱布做了个ct平扫,发现纱布里确实存在有一条致密影。后得知致密影是为防止手术时纱布遗留而设计。关腹时怀疑纱布遗留可做个床边透视或拍片可明确。 病例来源:ct3056 。由迎客松发布: http://www.radinet.com.cn/forum_view.asp?forum_id=4&view_id=11264 |